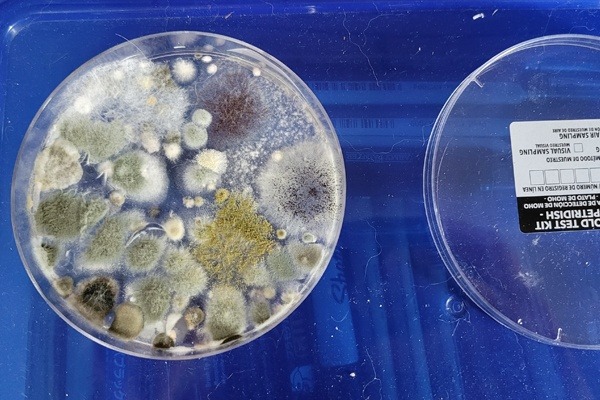
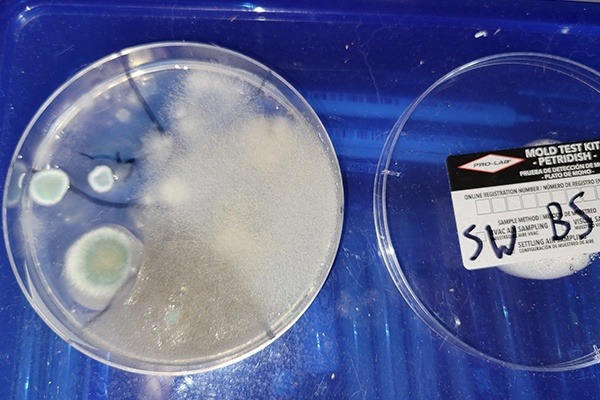
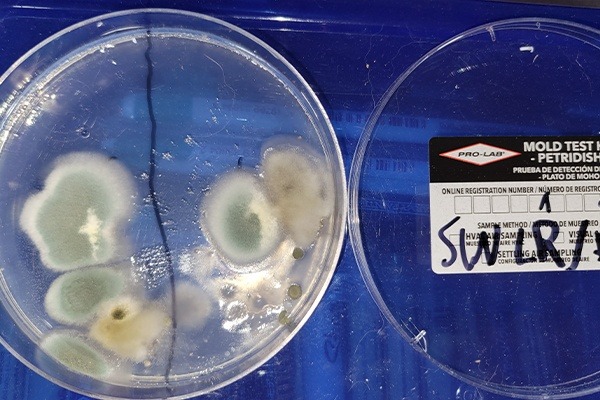
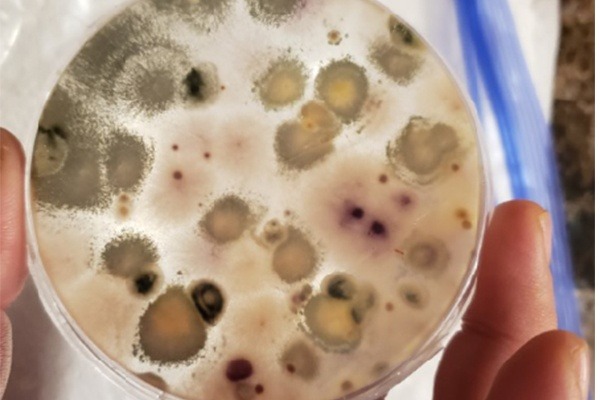

- T
- M
- R
We are in the midst of a life-changing emergency and we could really use your help.
Because of our landlord's negligence and refusal to deal with flood damage our entire home and everything we own is now infested with white mold. My family had to abandon the house, and all of our belongings.
I am currently living out of a hot garage with my mom, dad, two younger brothers and our kitties. We are all highly allergic to the mold and can't go back into the house,
To make matters worse my father is disabled with severe autonomic nervous system damage and Hypohidrosis (he can no longer sweat or control his body temperature). He has to use ice packs to try and cool down or he risks heatstroke and seizures. Because of the higher heat he's had two seizures already, one of which was so bad he went to the hospital by ambulance.
[UPDATE] I put this in an update already, but thought it was important to put here as well. Below is a picture of our environmental air tests.
The mold present is upwards of 3 times what is considered dangerous to breathe and at least 2 are considered toxic. It also explains the white mold covering everything, the green rings on our couches and chairs and, possibly the most disgusting, Myxomycetes - a "slime mold" "but is also considered an amoeba". It could explain why so much of our stuff has a "sticky" feeling to it. Gross.
All of the molds are considered allergens that create type I to type III allergic responses like asthma, blurry vision, pulmonary infections, pneumonia-like symptoms (which my dad had for 2 months earlier this year) and Anaphylaxis, among many other symptoms you can find in update 2. The mycotoxins they release can potentially have devastating, long-term health problems for all of us.
Photo's from the main floor showing either Alternaria and Basidiospores (white mold) on hard surfaces:
The bottom of my Dad's desk in the Living Room:

The side of my brother's bookshelf (Alternaria and Basidiospores):

Living room couch (Cladosporium mold):

The bottom of the Living room coffee table (Alternaria and Basidiospores):

A closeup of the Living room TV (Alternaria and Basidiospores):

The underside of my dad's leather office chair (Alternaria and Basidiospores):

The backside of my bedroom dresser (possibly Cladosporium or Basidiospores):
My dad's bedroom side table (Alternaria, Basidiospores and possibly Myxomycetes)

Mold coming up thru the floor in my brother's room. 
The floor under his bed (Alternaria or Basidiospores :

My mom's side table (Alternaria} :

The Bathroom floor. The mold has come up thru the floor and wall (Alternaria, Basidiospores}:

On a kitchen knife (Alternaria, Basidiospores}:

The book shelves behind my dad's desk (Alternaria, Basidiospores}:

The Basement, which has multiple types of mold present:





It has been a nightmare. When you talk about toxic mold most people think of black mold. I've never heard of white mold until now. It is just as toxic, if not worse, because is very hard to see until it blooms.
Before the environmental testing by CPH Inspections we had taken mold swabs and air samples ourselves. Here are the results:
Air sample from my dad's side table:
Basement Swab Sample:
Living Room and Dining Room Air Sample (main floor):
Basement Air Sample:
Our Landlord has refused to help.
Our house has flooded twice in the last year. Both times my dad had to fight the landlord to do anything about it. After the first flood the landlord left the wet moldering carpet in the basement for months. After my parents withheld rent he finally had it removed.
Then the basement flooded again. This time visible mold showed up on the basement furniture. Again my dad fought with the landlord as he was worried there might be mold in the damp drywall or behind it in the wood. The landlord refused to do anything about it and even yelled at my dad and said "You don't want mold? Then buy a house!" and hung up.
The air quality in the basement got so bad no one could go down there, but the upstairs was ok. My parents continued to fight the landlord about our living conditions with little luck. Our health also started deteriorating, but more on that in a moment.
Then on July 8th, 2021 we all woke up with trouble breathing, sore throats, coughing irritated eyes. After going into the basement my parents discovered white and green mold everywhere. My dad sent the landlord pictures of the mold and really chewed him out. The landlord promised to send out a mold specialist to look at it. More on that in an update.
Worse still, over the next week we found the our furniture on the main floor had become covered with mold too. We had had several high humidity days (90% and higher) prior to the 8th and apparently that created the perfect conditions for the mold to "bloom". We didn't realize that the upstairs had been infested with spores until it happened. White mold is almost impossible to see until it blooms, by then it's too late. It had covered books, posters, clothes... everything.
We tried to clean it with peroxide and white vinegar but the mold just came back. Because of our continued exposure my entire family is now extremely allergic to the mold. We had to give up on saving anything.
After that we had to abandon the home and pretty much everything in it.
Worsening Health:
My entire family have been dealing with sore throats and headaches, blurred vision, confusion, slurred words and vertigo since the second flood. At the time nobody really put it together that it was toxic mold exposure. We had thrown out the basement furniture and hadn't seen any visible mold in the basement and the main floor.
Since the flooding both my brothers have developed asthma, my dad (who is disabled) was sick for almost two months with a non-Covid lung infection, and was told he had developed COPD. On top of that he has also been diagnosed with Rheumatoid arthritis because of severe joint inflammation and pain. My 18 year old brother and I have both started having similar symptoms and our doctor want's us to be tested as well.
Toxic mold exposure causes joint inflammation and is often misdiagnosed as rheumatoid illness.
My mom lost her job as an administrative assistant due to worsening memory problems. She's also has to take Benadryl everyday since the last flood because of skin rashes.
My oldest brother has been getting painful rashes down his arms and stomach. My dad had huge, painful hives on his back. My asthma worsened. We've all had to go to the emergency clinic due to breathing difficulties several times and Riley had to go to the emergency room twice because he felt like he couldn't breathe.
Because of the pandemic our doctor's were concerned we had contracted Covid-19. We were tested multiple times over the last year, had chest x-rays and CT scans, but all the test came back negative. We are taking asthma medications, allergy meds and 3 different typed of inhailes, but they aren't helping much.
Our family doctor believes all of us are dealing with a severe allergic reaction to the mold and has referred us to both an Allergist and an Immunologist.
My brother's arm:
Hives and rash on my dad's back after wearing a shirt that had been in the basement:
My parents have told the landlord about our health problems but he couldn't care less.
Even our kitties have been sick with constant fungal infections in their ears, respiratory infections and leaky eyes despite the best efforts of our veterinarian.
A photo from June after Harley had her ears cleaned. Belly rubs were required for forgiveness:
Bosco's eye infection:
Now We Are Sleeping In the Garage:
The house is too toxic to live in, so we're all camped out in the garage until we figure out somewhere to go. We have no family in Michigan we can turn to and the friends my parents know can't take in a large family like ours. Not that we we would leave our kitties behind in that awful house. So we're just trying to make the best of a bad situation.
My brothers:

My dad & Bosco crashing in a chair a friend gave us:

My mom and her girl:

Gizmo found a box, so he's happy:
Bosco's favorite place to sleep, on my dad's lap. He is an amazing cat. Somehow he can sense when my dad is going to have a seizure and will jump on him, paw at my dad's face and lick his nose.
Bandit being the boss as usual:
Harley, always on the hunt for more belly rubs:
Our cats are all rescues that have come from bad homes and have learned to trust and love again. Our kitties are family, we won't abandon them.
I think my mom's favorite coaster says it best, even if it is covered in mold:

Our Renter's Insurance Doesn't Cover Mold Damage.
What We Are Asking For:
- Because of my dad's disability (he can't sweat or regulate his body temperature) our first priority is getting out of this hot garage and into a temperature controlled environment until we can find a new place. We found a couple of hotels that will accept pets.
- New clothes and food (we only have the clothes we were wearing when we left).
- After that is finding a house or apartment (first and last month's rent - estimated at most -$3200).
- Basic furniture necessities (beds, sheets, blankets, dishes, etc).
- Environmental testing of the house ($300 to start but will certainly be more before we get all the evidence we need).
- Help covering our legal case against the landlord (estimated -$3000 to get the ball rolling. In the long term we are probably looking a $5000 to $6000 before we're done).
- A full toxic mold exposure health screening, in depth mycotoxin and endotoxin testing for each of us if possible (which our state health insurance doesn't cover - estimated to be $3000 to $4000). Our lawyer says it's important for us to have documented lab results showing how the toxic mold exposure is directly responsible for our deteriorating health if we are going to have any chance of winning against the landlord.
Because of the severe allergic responses we've all had to the mold we can't risk taking anything with us. We can't take a chance of carrying the mold to a new home and having to go through all of this again.
No one should ever have to live like this.
Please help us fight back against the landlord. He can't be allowed to get away with this. All he will do is the bare minimum to cover up the mold and put the next family through this again after we're gone.
So I ask you to please consider donating or sharing our story.
I am creating this go fund me to help aid the financial situation of my family and to help relieve the burden on my father. My parents are rather old fashioned and didn't consider creating a GFM to help aid us. They have tried reaching out to many city, county, and state offices to try to find assistance and sadly there really is none. We are running out of options and as of today are basically homeless, living out of our truck and a garage while we try and figure things out.
Please feel free to reach out to us with any questions or advice about our situation, Thank you.
If you are interested in finding out more about how all of this happened I will be adding it in an update soon.

